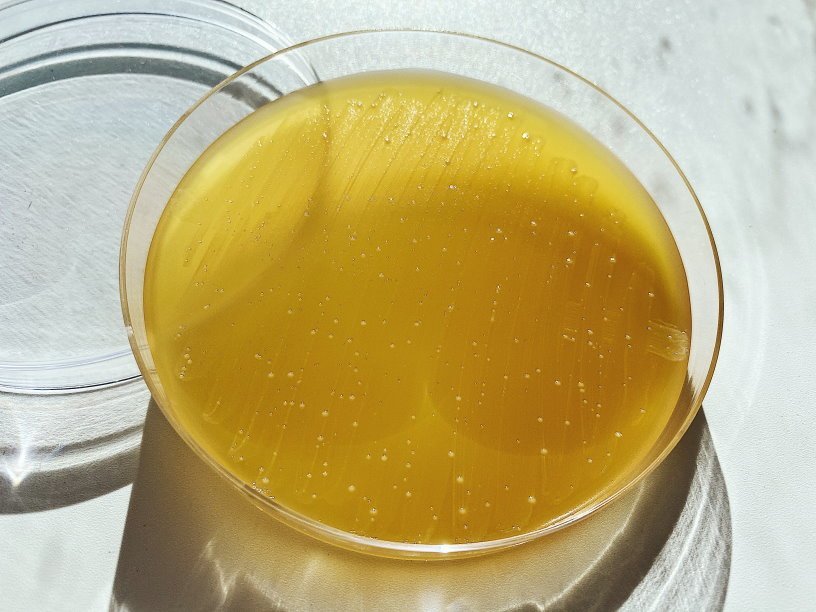

Екатерина Беленко: Промикробы: Атака клонов
Фото: Екатерина Беленко Малярия — это не одна болезнь, а целая группа трансмиссивных инфекционных заболеваний, передаваемых человеку при укусах самками комаров рода Anopheles, вызывается паразитическими протистами рода Plasmodium, преимущественно Plasmodium falciparum, но не только им. Малярийные комары живут почти во всех климатических зонах, за исключением субарктического, арктического поясов и пустынь. Однако мало одних комаров, для того чтобы существовал риск заражения, требуются условия для их быстрого размножения и переноса малярийного плазмодия. Такие условия достигаются в районах, где не бывает низких температур, имеются болота и выпадает много осадков. Поэтому малярия шире всего распространена в экваториальной и субэкваториальной зонах и относительно широко распространена во влажном субтропическом поясе.
⠀
Человек заражается малярийным плазмодием в момент укуса комара. Комар не может просто пить, он немного пускает слюни в ранку, тем самым впрыскивая одну из стадий жизненного цикла паразита. Жизненный цикл этот хорош и запутан, не буду грузить всеми деталями. Достаточно понимать, что конечный и желанный хозяин для плазмодия — комар. Только в его хрупком писклявом тельце происходит половой процесс плазмодиев. Заражение людей — так, оплошность, всё, что они делают, попав в человека, — это пытаются вернуться в комара, как Одиссей на Итаку. Но путь их не менее сложен и тернист. Вот попали они в кровь после укуса, там им не сидится, они проникают в клетки печени — гепатоциты. Там плазмодий занимается бесполым размножением: вжух — и вместо одной клетки уже 40 тысяч клеток.
⠀
Через пару-тройку недель плазмодиям надоедает тесная печеночная клетка и они снова выходят в кровь, где ловят эритроцитарный «убер». Для этого они крепятся к специфическим рецепторам на поверхности мембраны эритроцитов. Эти рецепторы, служащие мишенями для заражения, по-видимому, различны для разных видов малярийных плазмодиев. Проникнув в эритроцит, плазмодии снова начинают активно наращивать боевую мощь, множа и множа количество своих копий. Эритроциты не железные и не резиновые, они лопаются, а высвободившаяся армия может заражать новые эритроциты, ещё лавинообразно увеличивая свою численность. При укусе комара кровь зараженного попадает в желудок насекомого и цикл повторяется.
⠀
Симптомы малярии обычно следующие: лихорадка, озноб, боль в суставах, рвота, судороги, увеличенная селезёнка, нестерпимая головная боль. Малярийная инфекция смертельно опасна, особенно для детей и беременных женщин. Есть разные методы диагностики малярии, более современные — это ПЦР-диагностика и иммунохимические методы. Но проверенная временем классика всё ещё актуальна — выявление паразитов в мазках крови. Традиционно используют два типа мазков — тонкий и толстый. Тонкий мазок позволяет с большей надёжностью определить разновидность малярийного плазмодия, поскольку лучше сохраняется форма клеток паразита. Толстый мазок позволяет микроскописту просмотреть больший объём крови, поэтому этот метод чувствительнее, но внешний вид плазмодия при этом изменяется, что не позволяет легко различать разновидности плазмодия.
⠀
Иммунный ответ против малярийной инфекции развивается медленно. Он характеризуется малой эффективностью и практически не защищает от повторного инфицирования. Приобретённый иммунитет развивается после нескольких заболеваний малярией за несколько лет. Этот иммунитет специфичен к стадии заболевания, к виду и даже к конкретному штамму малярийного плазмодия. Но клинические проявления и симптомы уменьшаются с развитием специфического противомалярийного иммунитета. Одной из причин такого слабого иммунного ответа является нахождение малярийного плазмодия в клетках на протяжении большей части его жизненного цикла.
Смотрите также: Екатерина Беленко Промикробы: Вооружен и очень опасен Екатерина Беленко Промикробы: Плесень и липовый мёд Екатерина Беленко Промикробы: Кровавая среда Екатерина Беленко Промикробы: Потянуло на солененькое Новое Татьяна Пигарева Испания от И до Я Сергей Сергеев Русское самовластие. Власть и ее границы: 1462–1917 гг. Катерина Михалева-Эгер 350 лет современной моды Леонид Чутко Сил нет Катя Колпинец Формула грез Сергей Плохий Забытые бастарды Восточного фронта Дэвид Чиверс, Том Чиверс Цифры врут. Как не дать статистике обмануть себя Пол Стейнхардт Невозможность второго рода Стивен Хоффман Пять сил, изменяющих все Уолтер Айзексон Взломавшая код Рустам Александер Закрытые. Жизнь гомосексуалов в СССР 3D-каркасы для восстановления костной ткани Платиновый бутерброд для спинтроники